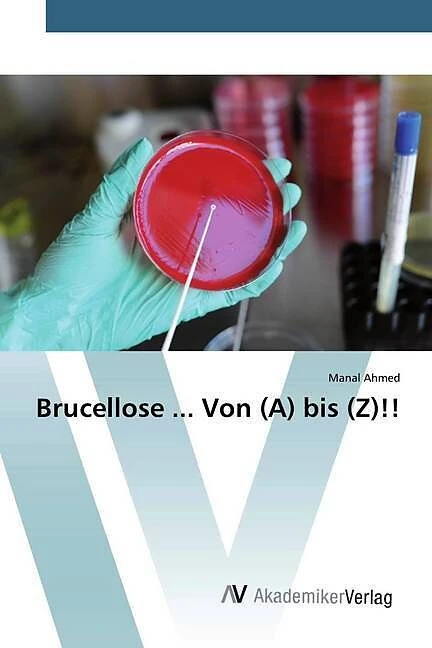

Wir verwenden Cookies und Analyse-Tools, um die Nutzerfreundlichkeit der Internet-Seite zu verbessern und für Marketingzwecke. Wenn Sie fortfahren, diese Seite zu verwenden, nehmen wir an, dass Sie damit einverstanden sind. Zur Datenschutzerklärung.
Brucellose ... Von (A) bis (Z)!!
Details
Die Brucellose ist eine der wichtigsten zoonotischen Krankheiten, die durch die Bakteriengattung Brucella verursacht wird. Brucella kann direkt oder indirekt vom Tier auf den Menschen übertragen werden, z.B. durch die Einnahme kontaminierter Lebensmittel, durch direkten Kontakt mit infiziertem Tiergewebe oder durch Einatmen kontaminierter Aerosole. Brucella kann in verschiedenen Körperflüssigkeiten wie Urin, Milch und Plazentaflüssigkeit ausgeschieden werden. Sie betrifft Menschen aller Altersgruppen und beiderlei Geschlechts. Die Brucellose ist eine alte Krankheit, die unter verschiedenen Namen bekannt ist, u.a. "Mittelmeerfieber", "Maltafieber", "remittierendes Magenfieber" und "unruhiges Fieber". Brucella-Organismen sind kleine aerobe, intrazelluläre Kokos-Bakterien, die sich hauptsächlich in den Fortpflanzungsorganen der Wirtstiere ansiedeln und zu Aborten und Sterilität führen. Obwohl der Mensch ein zufälliger Wirt ist, stellt die Brucellose als häufigste zoonotische Infektion weltweit noch immer ein großes Problem für die öffentliche Gesundheit dar.
Autorentext
Dr. Manal M. E. Ahmed wurde in Kairo - Ägypten - geboren. Sie studierte Veterinärmedizin an der Universität Kairo, wo sie erfolgreich promovierte. Sie arbeitet seit fast 25 Jahren auf dem Gebiet der Mikrobiologie und Immunologie. Ihr Hauptinteresse gilt der Entwicklung neuartiger immunologischer Instrumente für die pharmazeutische und diagnostische Industrie.
Weitere Informationen
- Allgemeine Informationen
- GTIN 09786200667144
- Sprache Deutsch
- Genre Mikrobiologie
- Größe H220mm x B150mm x T10mm
- Jahr 2020
- EAN 9786200667144
- Format Kartonierter Einband
- ISBN 978-620-0-66714-4
- Veröffentlichung 20.04.2020
- Titel Brucellose ... Von (A) bis (Z)!!
- Autor Manal Ahmed
- Gewicht 262g
- Herausgeber AV Akademikerverlag
- Anzahl Seiten 164